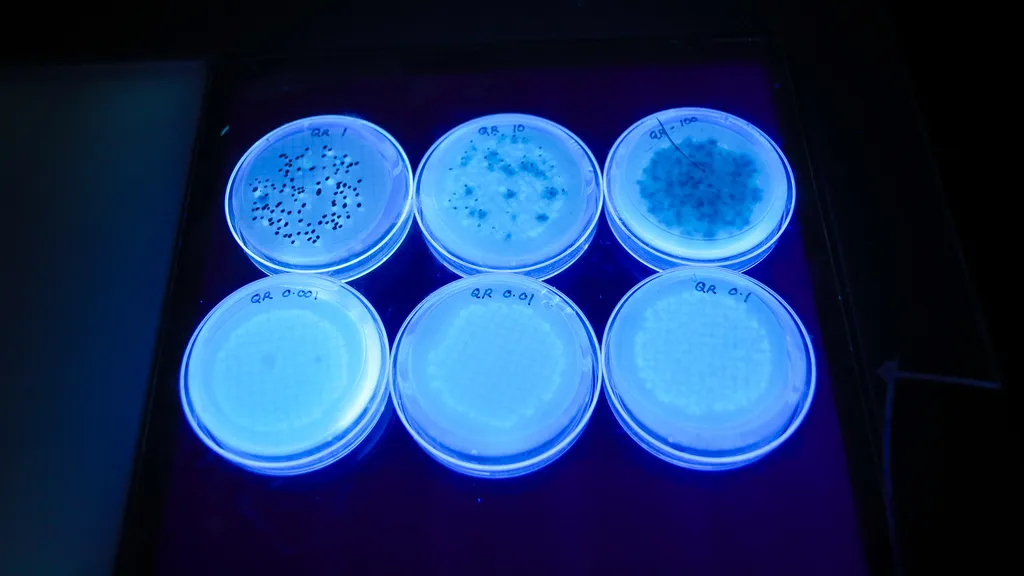

- September 09, 2024
- By Heidi Scott ’09
Early on summer mornings, while mist lingers on the river and great egrets pick their way along the shore, the Anacostia’s beauty rests easy. While the air is still cool, residents of Prince George’s County and D.C. bike, walk and row along a stretch of the Bladensburg waterfront.

But amid the tranquility, there is another perspective on the Anacostia: It’s a forgotten river that for decades has suffered from industrial pollution and sewage leaking from aging infrastructure—and this neglect is emblematic of environmental injustice on Washington, D.C.’s east side.
For those who care about the health of the river, these mornings are the best time to monitor for dangerous bacteria like E. coli that can indicate the presence of raw sewage.
That’s where the nonprofit Anacostia Riverkeeper and the Global FEWture Alliance, the latter funded by a University of Maryland Grand Challenges Institutional Grant, have stepped in, joining in a dynamic partnership that links the nonprofit’s volunteers to the CONSERVE Center’s laboratory testing capacity.
Amy Sapkota, MPower professor, principal investigator of the Global FEWture Alliance, director of the CONSERVE Center, and chair of the Department of Global, Environmental, and Occupational Health, is also a beginner rower who savors mornings on the water. “As both a researcher and a new member of the Washington Rowing School in Bladensburg, I'm thrilled that my team is partnering with Anacostia Riverkeeper to help protect this beautiful river and keep rowers and other recreationalists safe,” she said.
At this summer’s Paris 2024 Olympics, officials there monitored the Seine River in an attempt to reassure triathletes the river was safe for swimming. Similarly, Anacostia Riverkeeper and the Global FEWture Alliance are developing robust datasets that will help them advocate for precise, affordable solutions to the Anacostia’s microbial woes so the river may once again thrive as a safe natural resource for wildlife and humans. Swimming is currently illegal due to the health risks, such as gastrointestinal and respiratory illness, and eye, nose and skin infections.
The two volunteer citizen scientists one summer morning have known the Anacostia for decades. Gabe Horchler, a retiree who for 15 years rowed along the river to his job at the Library of Congress, said he’s seen improvements since the implementation of a plastic bag fee and recent sewer line repairs. But he and Pat Jackman, a U.S. Forest Service retiree who said she’s tired of the Anacostia getting a bad rap, have to navigate continuing plastic pollution, poison ivy, mosquitoes and muddy riverbanks while they test for pH, salt content and water temperature, as well as draw samples for laboratory testing.
Maureen Mitchell, Anacostia Riverkeeper’s education program manager, said the organization is dedicated to providing critical data to residents so they can make safe decisions about recreation.

“Anacostia Riverkeeper believes that everyone has the right to safely recreate in their local waterway,” she said. ”Our new partnership with UMD's CONSERVE Center builds on five years of existing data, and takes a monumental step toward identifying and eliminating bacterial sources in our watershed to achieve a swimmable river for all.”
Leading the laboratory side of the effort are CONSERVE team members: Postdoctoral Research Fellows Suhana Chattopadhyay and Michele Morgado, and Assistant Research Professor Leena Malayil. “Our partnership is advancing efforts to safeguard public health by characterizing fecal indicator bacteria and select pathogens and tracking the microbial sources of these contaminants in the Anacostia River,” said Chattopadhyay. “By collaborating closely with our local community, we aim to ensure recreational water safety and promote environmental stewardship, fostering a cleaner, healthier future for all.”
Graduate students Taiwo Alawode and Asangwing Formukong and several undergraduate interns are busy processing water samples and gathering pilot data on fecal indicators (E. coli and total coliforms) and recreational water pathogens (Vibrio species). They also plan to track the sources of these microorganisms–using molecular microbial source tracking approaches–and characterize the total and metabolically-active bacterial community using innovative DNA sequencing. Malayil views these techniques as essential to forward-looking solutions.
“We are determined to help improve the Anacostia, particularly as our climate continues to change, through science-based management and policy solutions that protect both this precious ecosystem and public health,” she said.
Topics
ResearchUnits
School of Public Health